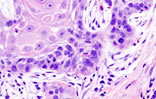
VPH

Metas del milenio sobre VIH exigen más prevención y educaciónLas metas del milenio en relación al VIH y al Sida son cero nuevas infecciones, cero muertes y cero discriminación. Al respecto Elia Sánchez, Médica infectóloga con 20 años de experiencia en el tratamiento de personas con VIH, comenta que lo que esto nos indica es que debemos optimizar la actuación en prevención y crear protocolos para reducir la transmisión vertical del virus; concienciar sobre el diagnóstico y tratamiento oportuno, y educar a la población con información veraz para acabar con los mitos sobre esta epidemia. (leer más) 
Cuidadores de personas con VIH y Sida, tan vulnerables como quien padece la enfermedadCuidar a una persona que tenga alguna condición crónica de salud no es tarea fácil, pues el propio organismo del cuidador puede deteriorarse hasta en la misma proporción de la persona que presenta la enfermedad si no se establecen pautas para proteger su salud. (leer más) |
Jóvenes deben prepararse para un inicio sano de la actividad sexualSi bien el Virus de Papiloma Humano (VPH) y el Virus de Inmunodeficiencia Humano (VIH) se transmiten de la misma forma, por vía sanguínea o por relaciones sexuales, y no tienen una relación estructural propiamente dicha, la literatura médica asegura que las personas con una infección preexistente de VPH corren más riesgo de contraer el VIH. A los fines de documentar esta información, StopVIH consultó a la Dra. Rosa Khalil Bittar, Médico Internista-Infectólogo... (leer más) 
Inestabilidad en despacho de antirretrovirales tiene en vilo a miles de personas con VIH en VenezuelaEn lo que va de año no se ha alcanzado la regularidad en la entrega de medicamentos antirretrovirales a través del Programa Nacional de Sida, por lo que sigue en riesgo la vida de miles de personas dependientes de las medicinas indicadas para tratar y controlar el Virus de Inmunodeficiencia Humano (VIH). (leer más) 
Positivos en Colectivo suma nuevas voluntades para luchar contra el VIHMauricio Gutiérrez, miembro del grupo dijo que la iniciativa surgió de la necesidad de compartir experiencias entre las personas con VIH, pues si bien reconoce que las ONG e instituciones públicas y privadas hacen importantes esfuerzos en educación, orientación y prevención, quienes han contraído la infección tienen otras necesidades de acuerdo a su vivencia de la enfermedad. (leer más) |
Algunos de nuestros aliados y colaboradores
